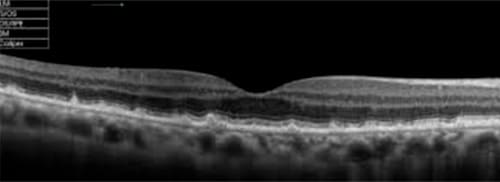

O que é a macula?
A mácula é uma pequena área no centro da retina onde estão localizados os cones fotorreceptores (células) especializados na visão de detalhes. Estes fotorreceptores transformam a luz que entra nos olhos em estímulos elétricos que são transmitidos ao cérebro para a formação da visão.
O que é DMRI?
A Degeneração Macular Relacionada a Idade (DMRI) é uma doença degenerativa da mácula, que geralmente acomete pessoas com mais de 50 anos, sendo a causa mais frequente de baixa acuidade visual nessa faixa etária.
Ela pode ser divida em 2 grupos: forma seca (drusas e atrofia geográfica) e forma exsudativa, (molhada ou úmida):
DMRI seca:
Também conhecida como DMRI não exsudativa, é o tipo mais comum e geralmente progride lentamente. Nessa forma, pequenas drusas (depósitos amarelados) se acumulam na mácula, causando uma deterioração gradual da visão central. A visão periférica normalmente não é afetada pela DMRI seca.
DMRI úmida: Também chamada de DMRI exsudativa, é menos comum, mas geralmente mais grave. Nesse tipo, novos vasos sanguíneos anormais se formam sob a retina e vazam fluidos e sangue, danificando a mácula. A visão central pode ser rapidamente afetada e distorcida, levando à perda de detalhes finos e visão embaçada.
Qual a causa da DMRI?
Os principais fatores de risco para o desenvolvimento da DMRI, incluem:
•Envelhecimento
•Histórico familiar da doença
•Tabagismo
•Hipertensão arterial
•Obesidade e sedentarismo Exposição excessiva à luz ultravioleta
Quais são os sintomas de DMRI?
Os sintomas iniciais são geralmente imperceptíveis.
Principais sintomas com evolução da doença:
•Baixa visão (progressiva ou abrupta)
•Visão distorcida (metamorfopsia)

Como é realizado do diagnóstico?
Com exames realizados por oftalmologista especialista em retina, incluindo:
•Fundo de olho (mapeamento de retina )
•Retinografia colorida e fluorescente
•Tomografia de coerência óptica (OCT)
•Angio oct (OCT-A)
Qual tratamento para DMRI?
Embora não haja cura para a DMRI, existem opções de tratamento disponíveis como:
•Uso de polivitamínicos e omega 3 (segundo estudos clínicos – AREDS 2)
•Aplicação de medicamentos (injeção intra-vítrea) em casos selecionados
•Mudança no Estilo de Vida:
•Parar de fumar
•Reduzir a ingestão de gordura
•Manter peso e pressão arterial controladas
•Aumentar ingestão de folhas verde (espinafre e couve-flor), ovos e frutas